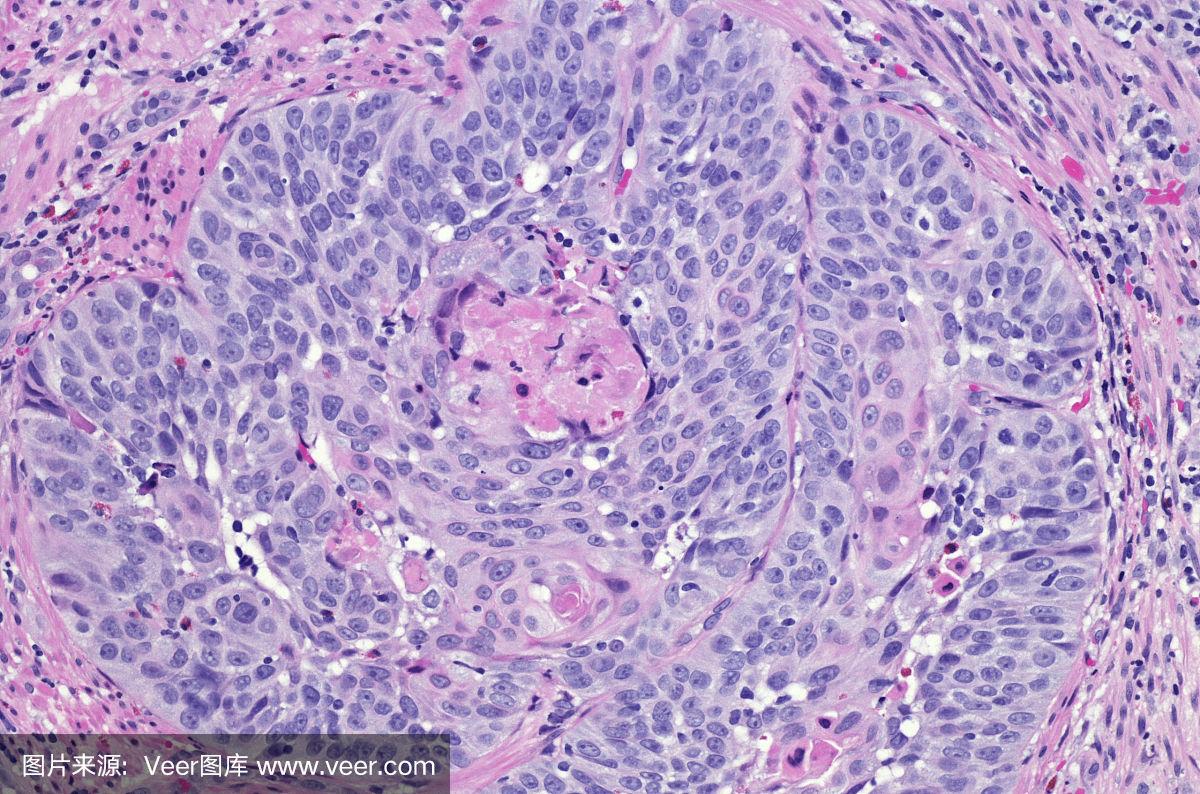

这两天突然胸口中间有个凹进去的位置堵得慌喘不过气
当肺部和胸膜发生了病变,就很容易出现疼痛感,特别是咳嗽和深呼吸的时候,会越来越严重胸膜炎所引起的疼痛感就相当于针刺感,当胸廓扩张幅度较大的时候,疼痛感就会加剧,患者喘不过气来当胸膜出现恶性肿瘤,除了疼痛还会伴有带血胸...
关节僵硬的原因有哪些(为什么更年期女性容易关节僵硬屈伸疼痛)
更年期是女性生命历程中的一个重要阶段,通常出现在45~55岁之间。在更年期,随着卵巢功能逐渐衰退,雌激素水平下降,不仅会出现潮热、盗汗、情绪波动、失眠等“更年期综合征”,很多女性还会出现关节僵硬、屈伸疼痛、活动受限。...
得了破伤风的症状(破伤风的临床表现)
一、破伤风【病因】破伤风( tetanus )是常和创伤相关联的一种特异性感染。除了可能发生在各种创伤后,还可能发生于不洁条件下分娩的产妇和新生儿。病菌是破伤风梭菌,为专性厌氧,革兰染色阳性;平时存在于人畜的肠道,随...
亚硝酸盐是什么(食品安全风险解析关于亚硝酸盐的科学解读)
入夏以来,食物中毒呈上升趋势,其中一项主要原因是食用亚硝酸盐超标的卤肉制品、凉拌菜等引起食物中毒。那么,亚硝酸盐是什么?如何引起食物中毒的发生?有何相关标准和法规?消费者和相关食品生产经营者应如何防范亚硝酸盐导致的食...
盆底康复治疗有用吗?(盆底康复到底是不是智商税)
产后宝妈正在进行骨盆修复。红网时刻新闻11月16日讯(通讯员 黄颖)盆底肌看不见摸不着,为什么要修复?有很多宝妈认为盆底康复是“智商税”,甚至有很多宝妈认为“我是剖宫产的,产后不需要修复盆底肌”“漏尿只是小事,不用治...

京公网安备11000000000001号
京ICP备11000001号